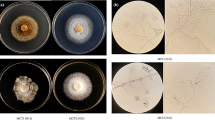

Abstract
Key message
Highest xanthone contents were found in Hypericum pulchrum and H. annulatum untransformed roots. The best anti- Candida activity was obtained for hairy roots extracts of H. tetrapterum clone 2 ATCC 15834.
Abstract
Extracts of root cultures, hairy roots and cell suspensions of selected Hypericum spp. were screened for the presence of xanthones and tested for their antifungal activity against Candida albicans strain ATCC 10231. At least one of the following xanthones, 5-methoxy-2-deprenylrheediaxanthone; 1,3,6,7-tetrahydroxyxanthone; 1,3,5,6-tetrahydroxyxanthone; paxanthone; kielcorin or mangiferin was identified in methanolic extracts of the untransformed root cultures. The highest total xanthone content, with five xanthones, was found in untransformed H. pulchrum and H. annulatum root cultures. Hairy roots and the controls of H. tetrapterum contained 1,7-dihydroxyxanthone, while hairy root cultures and the corresponding controls of H. tomentosum contained toxyloxanthone B, 1,3,6,7- and 1,3,5,6-tetrahydroxyxanthone. Two xanthones, cadensin G and paxanthone, were identified in cell suspension cultures of H. perforatum. Their content increased about two-fold following elicitation with salicylic acid. The anti-Candida activity of the obtained extracts ranged from MIC 64 to >256 µg ml−1. Among the extracts of Hypericum untransformed roots, the best antifungal activity was obtained for extracts of H. annulatum grown under CD conditions. Extracts of hairy roots clones A4 and 7 ATCC15834 of H. tomentosum and clone 2 ATCC15834 of H. tetrapterum displayed inhibition of 90 % of Candida growth with 256 μg ml−1. Extracts from chitosan-elicitated cells did not show antifungal activity.
Similar content being viewed by others
Explore related subjects
Discover the latest articles, news and stories from top researchers in related subjects.Avoid common mistakes on your manuscript.
Introduction
Members of the genus Hypericum L. are distributed worldwide, but are found predominantly in temperate zones of the Earth. Up to the present, almost 500 species of the genus have been documented (Nürk et al. 2013), but only ca. 40 % of them have been phytochemically characterized (Crockett and Robson 2011). Extracts of the species of the genus Hypericum, natural sources of bioactive compounds, display numerous activities in multiple bioassays (recently reviewed by Wolfle et al. 2014). Among the many secondary metabolites produced by Hypericum spp., xanthones are becoming the focus of interest in current research because of their powerful antioxidant, antibacterial, antitumoral and antifungal activities (reviewed by Fotie and Bohle 2006; El-Seedi et al. 2010; Tala et al. 2013).
In Hypericum, xanthones are mainly accumulated in the roots. In fact, the first xanthone identified in Hypericum spp. was maculatoxanthone from the roots of H. maculatum Crantz (Arends 1969). The occurrence of hydroxy- and methoxy- substituted xanthones in roots of H. androsaemum L. is mentioned in the study of Nielsen and Arends (1979). Thereafter, four new xanthones were isolated from the roots of H. roeperanum Schimp. ex A. Rich. (Rath et al. 1996). Crockett et al. (2011) isolated three xanthones from root extracts of H. perforatum: 1,6-dihydroxy-5-methoxy-40,50-dihydro-40,40,50-trimethylfurano-(20,30:3,4)-xanthone;4,6-dihydroxy-2,3- dimethoxyxanthone and cis-kielcorin, and a new inhibition of the plant pathogenic fungi Phomopsis obscurans and Plasmopora viticola was observed (Crockett et al. 2011). Moreover, the antifungal activity of H. perforatum root extracts has been evaluated against a broad panel of human fungal pathogens, including Candida spp. (Tocci et al. 2011). Candida is a yeast that causes the greatest number of fungal deseases. Infections caused by Candida spp. affect 70–75 % of women at least once during their life (Sobel 2007).
In vitro root cultures represent suitable biotechnological tools for the production of standardised extracts and for the isolation of bioactive substances (Pasqua et al. 2005; Tocci et al. 2012). The biotechnological potential for xanthone production in elicited root cultures of H. perforatum has been widely studied (Tocci et al. 2011, 2013b). Tusevski et al. (2013a, b) also determined significant quantities of xanthones in hairy roots of H. perforatum following transformation by Agrobacterium rhizogenes. Xanthones have also been identified as major metabolites in cell suspension cultures of H. perforatum (Pasqua et al. 2003). To improve xanthone biosynthesis in cell suspension cultures, several biotic elicitors such as Colletotrichum gloeosporioides, Agrobacterium tumefaciens, Agrobacterium rhizogenes and chitosan have been applied (Conceição et al. 2006; Franklin et al. 2009; Tocci et al. 2010; Tusevski et al. 2014). Other studies have cited the use of elicitors, such as salicylic acid, to stimulate hypericins and hyperforins in cell supension cultures (Gadzovska et al. 2013).
The aims of this study were (1) to determine the xanthone profile in root culture extracts of several previously unstudied Hypericum species; (2) to evaluate the capacity for xanthone production of H. tetrapterum Fries. and H. tomentosum L. hairy roots; (3) to ascertain the effect of elicitation of a cell suspension culture of H. perforatum with chitosan and salicylic acid on xanthone content and; finally, (4) to assess the antifungal activity of these extracts against Candida albicans.
Materials and methods
Plant material and culture conditions
Root and hairy roots cultures
Roots of eight species of the genus Hypericum (H. humifusum L., H. annulatum Moris., H. tetrapterum Fries., H. tomentosum L., H. maculatum Crantz., H. rumeliacum Boiss., H. pulchrum L. and H. kouytchense H. Lév.) were selected for this experiment. The roots were isolated from in vitro-grown plants derived from stock cultures cultivated on hormone-free medium containing Murashige-Skoog’s (MS) salt mixture (Murashige and Skoog 1962), Gamborg’s B5 vitamins (Gamborg et al. 1968), 30 g l−1 sucrose and 2 mg l−1 glycine. The culture medium was solidified with 7 g l−1 agar, and the pH was adjusted to 5.6 before autoclaving. Isolated roots were transferred into liquid medium of the same composition. Root cultures were grown in Erlenmeyer flasks at 23 ± 1 °C, 40 % relative humidity under either continuous darkness (CD) or exposed to a 16/8 (light/dark) photoperiod with artificial irradiance of 26 μmol m−2 s−1 on a rotary shaker (120 rpm). The root cultures with the growth index (GI) <2 at the end of culture period were excluded from further experiments. Consequently, only H. annulatum was cultivated under conditions of both continuous darkness and 16/8 photoperiod, whereas the remaining root cultures were grown as follows: (CD) H. humifusum, H. kouytchense, H. pulchrum; (16/8) H. tetrapterum, H. maculatum, H. tomentosum, H. rumeliacum. The standard and hairy root cultures were subcultured every 18–23 days. The growth dynamics of the listed Hypericum species were determined gravimetrically by measuring fresh weight increases on the 2nd, 5th, 7th, 9th, 12th, 14th, 16th, 19th and 22nd days. The initial weight of all samples was adjusted to 0.5 g FW of roots, which were immersed into 10 ml of hormone-free liquid MS media. The GI was calculated as follows:
Roots were harvested from the liquid media at the end of the culture period, dried in an oven at 40 °C until reaching a constant weight (48–72 h). This dry biomass (DW) was used for preparation of extracts for xanthone analysis and antifungal testing against C. albicans strain ATCC 10231. Hairy root cultures of H. tomentosum and H. tetrapterum had been previously established via transformation with wild-type agropine strains of Agrobacterium rhizogenes, A4 and ATCC 15834 (American Type Cultures Collection), and their transgenic character was proved (Komarovská et al. 2009) (Table 1). Before using the hairy root cultures in this experiment, the presence of the rol genes (rolA + rolB) was repeatedly determined by PCR amplification using specific primers as described by Zdravkovic-Korac et al. (2004); rolC, as described by Di Guardo et al. (2003), and rolD, by Komarovská et al. (2009). Roots grown under photoperiod conditions showed the lowest biomass increases among all species tested so the hairy roots were grown only in continuous darkness.
The culture conditions in the dark and the procedure for determination of growth kinetics were the same as for the root cultures described above.
Initiation, characterization and elicitation of cell suspensions
Cell suspension cultures, initiated from callus cultures of leaf origin, were derived from diploid H. perforatum plants. Two grams of whitish soft callus was resuspended in 100 ml of liquid medium containing MS macro and microelements (Murashige and Skoog 1962), Gamborg’s B5 vitamins (Gamborg et al. 1968), 30 g l−1 sucrose and 2 mg l−1 glycine, supplemented with 4.5 μM 2,4-dichlorophenoxyacetic acid, 0.46 μM kinetin and 0.44 μM 6-benzylaminopurine (Pretto and Santarém 2000), adjusted to pH 5.6 prior to autoclaving. Cell suspensions were placed on an orbital shaker at 120 rpm and cultured at 23 ± 1 °C, 40 % relative humidity under continuous darkness, which is beneficial for biomass production. The cultures were subcultured every 10–13 days. The growth dynamics were determined by the dry weight increase in cell biomass harvested on the 2nd, 4th, 6th, 8th, 10th and 12th days of culture after drying for 3 days at 40 °C, according to Tocci et al. (2012). The growth index was calculated as described in Sect. “Root and hairy roots cultures”. On the 4th day of subculture, the level of cell ploidy was assessed. One millilitre of general purpose buffer (Loureiro et al. 2007) was added to the cell suspension in a ratio of 1:1, and the suspension was filtered through nylon sieve mesh with a pore size of 76 μm. 50 μl RNase was then added, along with the same amount of propidium iodide. Cells in test-tubes were chilled on ice for 20 min and then quantitatively analysed using a flow cytometer (PartecCyFlow ML, Germany). The cell suspension cultures were elicited on the 4th day of subculture with 10 mg l−1 chitosan dissolved in 0.1 % acetic acid (CH) (Fluka, Iceland), 50 μM SA salicylic acid (SA) (Duchefa, Netherlands) and combinations thereof.
HPLC analysis of xanthones
One hundred milligrams of dried untransformed roots, hairy roots and cell suspensions were ground with pestle and morter and extracted three times with methanol (HPLC grade, Carlo Erba Milan, Italy) at a solvent: biomass ratio of 10 ml: 100 mg DW, then transferred into an ultrasonic water bath for 20 min. Subsequently, the extracts were placed in a dark location and macerated overnight at room temperature. Extracts were filtered and dried with a rotavapor. The dry extracts were re-dissolved in 2 or 4 ml of methanol and then analysed by gradient high-performance liquid chromatography (HPLC). Xanthones in cell suspension cultures were analysed 1, 3 and 5 days after the addition of an elicitor. Cells without treatment were referred to as controls. The HPLC analysis of the extracts was performed using an instrument consisting of a pump (Waters 1525 Binary HPLC Pump) equipped with a UV detector (Waters 2487 Dual λ Detector) and a reverse-phase C18 column (4.6 × 150 mm; 5 μm; waters). The extract capacity was determined by linear gradient elution, using a modified version of a method described by Dias et al. (1999). The mobile phase consisted of 100:0.1 (v/v) water:formic acid (component A) and methanol (component B) (Carlo Erba, Milan, Italy) (gradient elution: time 0, 90 % A and 10 % B; time 2 min, 70 % A, 30 % B; time 8 min, 60 % A, 40 % B; time 13 min, 50 % A, 50 % B; a plateau of 2 min; time 23 min, 30 % A, 70 % B; a plateau of 5 min; time 38 min, 20 % A, 80 % B; a plateau of 12 min; time 55 min, 5 % A, 95 % B; a plateau of 10 min; time 70 min, 90 % A, 10 % B), with a flow rate of 1.0 ml min−1 and an injection volume of 20 μl. The absorbance of the compounds at 260 and 320 nm was measured using the external standard method. As a references, a mixture of 1,3,6,7-tetrahydroxyxanthone and 1,3,5,6-tetrahydroxyxanthone, kielcorin, toxyloxanthone B, paxanthone, cadensin G, all of which had been previously purified and spectroscopically characterized in the laboratory of the University Sapienza in Rome, Italy, was used. 1,7-dihydroxyxanthone and 5-methoxy-2-deprenylrheediaxanthone B were extracted from regenerated roots of H. perforatum subsp. angustifolium. Biyouxanthone D was added to the described standard xanthone mixture for HPLC analysis of hairy root culture extracts. Xanthones were quantified as equivalents of paxanthone (Tocci et al. 2011, 2012) at 260 nm and all measurements were made in triplicate.
Antifungal susceptibility tests
For the antifungal evaluation, C. albicans strain ATCC 10231 was obtained from the American Type Culture Collection (ATCC, Rockville, MD, USA), and used in tests. The strain was stored and grown in accordance with the procedures published by the Clinical and Laboratory Standards Institute (CLSI, 2008). The broth microdiluition method was performed to evaluate the antifungal activity according to a standardised method for yeast (CLSI, 2008). Fluconazole (Sigma Aldrich, St. Louis, Missouri, USA) was used as a positive control. Fluconazole and dry root or cell extracts were diluted to a final concentration as follows: the final amounts ranged from 0.125 to 64 μg ml−1 for fluconazole and, for the total dry sample extracts, from 0.5 to 256 μg ml−1. The extracts were initially dissolved in dimethyl sulfoxide at concentrations 100 times higher than the highest desired test concentration and then diluted in the test medium to the appropiate concentration. The C. albicans ATCC 10231 was cultivated on Sabouraud dextrose agar and incubated at 35 °C. An inoculum was taken after 24 h of microorganism cultivation. Colonies were subsequently resuspended in 5 ml of sterile saline solution and vortexed for 15 s. The density of the cells was adjusted spectrophotometrically measuring, at 560 nm, to obtain a C. albicans stock suspension of 1–5 × 106 cells ml−1. Microdilution trays containing 100 μl of serial two-fold dilutions of fluconazole or cell/root extracts in RPMI 1640 medium (Sigma Aldrich, St. Louis, Missouri, USA) were inoculated with the C. albicans suspension adjusted to a final inoculum concentration of 5.0 × 102–2.5 × 103 cells ml−1. The trays were incubated at 35 °C and C. albicans growth was observed after 48 h. The minimal inhibitory concentration 50 (MIC50) was the lowest concentration that showed ≥50 % growth inhibition compared with the drug-free control. The MIC90 was the lowest drug concentration that caused ≥90 % growth inhibition compared to the control, and the MIC100 was equal to 100 % growth inhibition.
Results
Growth characteristics of the cultures
The growth of the untransformed roots (Fig. 1a, b) and hairy roots (Fig. 1c, d) was determined by assessing the fresh weight (FW) increase and the growth index (GI). As expected, the growth of hairy roots was faster than that of the corresponding untransformed roots. While the biomass of untransformed roots of H. tetrapterum or H. tomentosum increased towards the end of the subculture 2–3 times, depending on the light conditions, the hairy root biomass was enhanced 2- to 10-fold, depending on the clone. The highest root biomass (GI = 8.44) was detected in hairy roots of H. tomentosum clone e, transformed by A. rhizogenes A4 (Fig. 1c). However, no correlation between the biomass production and the type of integrated rol gene(s) was evident. Among the untransformed root cultures of Hypericum species, the highest biomass production was detected in dark-grown H. annulatum (GI = 3.6) (Fig. 1a). Cell suspensions of H. perforatum were characterized by their cell morphology, growth kinetics and ploidy level. They consisted mainly of cell aggregates of variable size and single spherical and oval-shaped cells with diameters ranging from 25 to 120 µm and large vacuoles. The subculture interval lasted 12 days, with exponential growth occurring between the days 4 and 8 (Fig. 1C). The GI at the end of subculture reached the value of 1.99. The cell suspension cultures were also variable as to the ploidy level. Flow cytometry screening revealed several ploidy levels (2C, 4C, 8C, 16C) with a prevalence of tetraploid cell populations.
Growth kinetics of untransformed roots cultured in the dark (a) and 16/8 h photoperiod (b), hairy roots of H. tomentosum (c), hairy roots of H. tetrapterum (d) control cell suspension cultures (e). Error bars represent standard deviation (SD) based on triplicate measurements of biomass fresh weight. 16/8 photoperiod; CD continuous dark; HTo H. tomentosum, HTe H. tetrapterum
Xanthone profile of the untransformed roots of Hypericum spp. grown under CD conditions
Phytochemical analysis of in vitro-grown untransformed roots cultured under CD conditions revealed great interspecific variation in both the total content of xanthones and the presence of individual xanthone types (Table 2). The root cultures of H. pulchrum and H. annulatum, cultured under CD conditions, were characterized by having the highest total xanthone content and five xanthones were identified: 3 xanthones occurred in both species, paxanthone was present in H. pulchrum and methoxy-2-deprenylrheediaxanthone B occurred in H. annulatum. It is noteworthy that the root cultures of H. pulchrum had the highest content of xanthones, but the slowest growth of all investigated cultures. Only one xanthone was identified in the extracts of H. humifusum and the lowest total xanthone content was determined in the root cultures of H. kouytchense.
Xanthone profile of the untransformed roots of Hypericum spp. grown under 16/8 h photoperiod
In the root cultures of five Hypericum spp. cultured under 16/8-h photoperiod, the total xanthone content varied between 0.5 and 1.4 mg/g DW with the highest content identified in H. tomentosum, which was characterized by slow growth. While the presence of mangiferin was detected in all investigated species, methoxy-2-deprenylrheediaxanthone B was found only in H. tetrapterum. 1,3,6,7 and 1,3,5,6-tetrahydroxyxanthones were determined in all species except for H. rumeliacum. The content of these xanthones in H. tomentosum was about 2 to 3 times higher than in H. tetrapterum, H. maculatum and H. annulatum (Table 3).
Xanthone profile of hairy roots
In all hairy roots clones of H. tetrapterum, 1,7-dihydroxyxanthone was identified at a concentration about 30 times higher than in the corresponding control (Table 4). The extracts of H. tomentosum hairy roots contained toxyloxanthone B, 1,3,6,7- and 1,3,5,6-tetrahydroxyxanthone (Table 4). In contrast to H. tetrapterum, the total xanthone content in extracts of the transgenic clones of H. tomentosum did not exceed the content in the control by more than two-fold. It should be noted that the control roots grown under photoperiod (Table 3) or under dark conditions (Table 4), both for H. tetrapterum and H. tomentosum, contained different xanthones.
Production of xanthones in elicited cell suspension cultures of H. perforatum L
Xanthone production was determined in cell suspensions on the 5th, 7th and 9th days of culture, corresponding to the 1st, 3rd and 5th days after elicitation. Control cell suspension cultures produced on average 0.238 ± 0.012 mg g−1 DW of total xanthones. The highest total xanthone content was detected 24 h after elicitation with SA, and gradually decreased until the beginning of the stationary phase (Fig. 2). In contrast, elicitation with CH or CH with SA resulted in only slight increase of the total xanthone content as compared to the control. Two xanthones, paxanthone and cadensin G, were identified in all samples. At the beginning of the elicitation treatment, the content of the latter was several times higher, while the content of both xanthones was comparable at the onset of the stationary phase.
The content of xanthones (mg g−1 DW) in cell suspension cultures. Figure shows production of xanthones in control samples (the 4th day) and samples after elicitation on the 5th, 7th and 9th day of culture. Error bars represent SE (standard errors) based on three independent measurements. C control, CH elicitation with chitosan, SA elicitation with salicylic acid and combination of them SA+CH; P paxanthone, CG cadensin G, T total xanthone content; DW dry weight
Antifungal activity of Hypericum extracts
The antifungal activity of the extracts from Hypericum untransformed root cultures, hairy roots and cell cultures against C. albicans ATCC 10231 was evaluated (Table 5). Among the Hypericum untransformed roots, the best antifungal activity was obtained for H. annulatum grown under CD conditions, with MIC 50 value of 128 μg ml1. Anti-Candida activity was also observed for hairy roots extracts of H. tomentosum (clone A4 and clone 7 ATCC 15834) and H. tetrapterum (clone 2 ATCC15834 and clone 2 A4), with MIC50 s ranging from 128-256 μg ml−1 and from 64 to 128 μg ml−1, respectively. No antifungal activity against C. albicans was found for extracts of elicited and non-elicited H. perforatum cells (Table 5).
Discussion
Xanthones are among the most common compounds isolated from the plants of the genus Hypericum, which is considered as a rich source of xanthones and derivatives that have a wide range of pharmacological effects (reviewed by Fotie and Bohle 2006; El-Seedi et al. 2010; Tala et al. 2013). Xanthones are present predominantly in the roots and, with some exceptions, can be found in the aerial parts (Kitanov and Nedialkov 1998). Since the first isolation of maculatoxanthone from H. maculatum (Arends 1969), several new xanthones have been isolated and identified from H. perforatum (Crockett et al. 2011; Li et al. 2013), H. riparium (Tala et al. 2013) and H. oblongifolium (Ali et al. 2014). Underground plant organs of H. perforatum, grown under controlled in vitro conditions, accumulate 27 times more xanthones than the roots of wild plants (Tocci et al. 2013a). In this study, we analysed xanthone accumulation in the root cultures of nine Hypericum species that had not previously been investigated. Four of them were cultured under CD and five under 16/8 h photoperiod conditions. Only one species, H. annulatum, was cultured under both CD and 16/8-h photoperiod conditions. The species grown under photoperiod conditions always showed lower total xanthone content. The highest total xanthone content, with five xanthones identified, was recorded in the root cultures of H. pulchrum and H. annulatum, respectively, both cultured under continuous darkness. Root cultures of H. annulatum were characterized by the highest growth index of the nine studied species, both under CD and 16/8-h photoperiod conditions, but under conditions of darkness, xanthone content was much higher than under photoperiod conditions (2.7 and 0.5 mg/g DW, respectively). The extracts obtained from H. annulatum roots, cultured under CD conditions, displayed good antifungal activity against C. albicans. Root cultures of H. tomentosum, H. tetrapterum, H. annulatum, H. rumeliacum and H. maculatum, cultured under 16/8-h photoperiod conditions, did not vary markedly as to the biomass increase and composition and total content of xanthones with the exception of H. tomentosum with the highest total xanthone content.
The biosynthesis of xanthones in the in vitro-cultured roots seems to be sensitive to exogenous stimuli such as nutrients or hormones (Tocci et al. 2012) or elicitors (Tocci et al. 2011, 2013b), the application of which may result in increased (sometimes transient) production of xanthones. Comparison of the total xanthone content and the number of identified individual xanthones in the roots of H. annulatum cultured under both CD and 16/8-h photoperiod conditions revealed about five times higher total xanthone content and higher diversity of xanthones in CD condition-cultured roots.
A high diversity of xanthones was previously detected in the transgenic hairy roots of H. perforatum (Tusevskiet al. 2013a), which makes the system promising for enhanced xanthone production. The authors also reported on altered biosynthetic potential of hairy root cultures grown in the dark and under photoperiod conditions (Tusevski et al. 2013b). We have analysed the content of xanthones in several clones of hairy root cultures of H. tomentosum and H. tetrapterum developed in our laboratory. The total content of xanthones in hairy roots of both species showed a positive correlation with the detected antifungal activity, although the spectrum of individual xanthones identified in the extract differed. In all hairy root clones of H. tetrapterum, we identified 1,7-dihydroxyxanthone while in the transgenic clones of H. tomentosum, we found, along with 1,3,6,7- and 1,3,5,6-tetrahydroxyxanthone, biyouxanthone D and toxyloxanthone B in higher quantities than reported from root cultures of H. perforatum (Tocci et al. 2013b).
Xanthones are compounds that are synthesized even by undifferentiated cells. They are the main metabolic products in suspension cultures and undifferentiated calli (Pasqua et al. 2003).
In cell suspension cultures of H. perforatum, we indentified two xanthones, paxanthone and cadensin. Paxanthone was first isolated from cell cultures of H. patulum by Ishiguro et al. (1993). Later, Ishiguro et al. (1995) isolated prenylated xanthones and their cyclization products from the cell cultures of the same species. The accumulation of high levels of tetrahydroxyxanthones in calli and suspended cell cultures of H.androsaemum, dependent on hormone supplementation, and H. perforatum was reported by Dias et al. (2000, 2001). El-Mawla (2005) identified 1,7-dihydroxanthone, 1,3,7-trihydroxanthone and three tetrahydroxyxanthones in cell cultures of H. gnidioides grown in Gamborg´s B5 medium in the dark. A high content of xanthones in undifferentiated calli of H. perforatum was reported by Mulinacci et al. (2008). In order to increase xanthone biosynthesis in cultured cells, we applied two elicitors, SA and CH, either alone or in combination. Although we recorded more than a two-fold increase in xanthone content 24 h after the application of SA, this increase did not persist during the following days of culture. The weak response to elicitor treatment may be due to the genetically and morphologically heterogenous composition of the culture. The use of fungal or bacterial elicitors yielded better results. Conceição et al. (2006) treated cell cultures of H. perforatum, primed with SA or MeJA, with the fungal elicitor Colletotrichum gloeosporioides, and recorded an increased xanthone production of 12-fold as compared to the control. A similar increase was achieved by Franklin et al. (2009), who used the elicitor Agrobacterium tumefaciens. In addition, these authors were able to identify four de novo synthesized xanthones, indicating that xanthones play a dual function: acting in plant defence to protect against biotic stress and oxidative damage and as phytoalexins to impair the pathogen growth. Our accumulated results indicate that increased xanthone synthesis is a part of systemic defence response in Hypericum species.
In summary, this work presents new results of xanthone production by root cultures of several previously unstudied Hypericum species. In addition, xanthone production was studied in transgenic clones of two Hypericum species, H. tomentosum and H. tetrapterum, which along with previously reported H. perforatum transgenic hairy root cultures, are among the most promising experimental systems for the study of the regulation of xanthone biosynthesis and prospective biotechnological production. Extracts from samples with the highest contents of xanthones exhibited antifungal activity against C. albicans.
Author contribution statement
DZ, AM, JH, performed all the in vitro experiments, acquisited the data and prepared the figures and tables; AM performed the cytofluorimetric analysis on cell suspensions, AM, DZ and GDA carried out the chemical extraction and HPLC analysis of the in vitro -grown material; AV acquisited and interpretated chemical data; FDD and GS performed and interpreted the antifungal activity tests; EC and GP coordinated all stages of the experimental work and drafted the manuscript. All authors read and approved the manuscript.
References
Ali M, Latif A, Zaman K, Arfan M, Maitland D, Ahmad H, Ahmad M (2014) Anti-ulcer xanthones from the roots of Hypericum oblongifolium Wall. Fitoterapia 95:258–265
Arends P (1969) Maculatoxanthone, a new pyranoxanthone from Hypericum maculatum. Tetrahedron Lett 55:4893–4896
Conceição LFR, Ferreres F, Tavares RM, Dias ACP (2006) Induction of phenolic compounds in Hypericum perforatum L. cells by Colletotrichum gloeosporioides elicitation. Phytochemistry 67:149–155
Crockett SL, Robson NKB (2011) Taxonomy and chemotaxonomy of genus Hypericum. Med Aromat Plant Sci Biotechnol 5:1–13
Crockett SL, Poller B, Tabanca N, Pferschy-Wenzig EM, Kunert O, Wedge DE, Bucar F (2011) Bioactive xanthones from the roots of Hypericum perforatum (common St John’s wort). J Sci Food Agric 91:428–434
Di Guardo A, Čellárová E, Koperdáková J, Pistelli L, Ruffoni B, Allavena A, Giovannini A (2003) Hairy root induction and plant regeneration in Hypericum perforatum L. J Genet Breeding 57:269–278
Dias ACP, Seabra RM, Andrade PB, Fernandez-Ferreira M (1999) The development and evaluation of an HPLC-DAD method for the analysis of the phenolic fractions from in vivo and in vitro biomass of Hypericum species. J Liq Chrom Rel Technol 22:215–227
Dias ACP, Seabra RM, Andrade PB, Ferreres F, Fernandes-Ferreira M (2000) Xanthone biosynthesis and accumulation in calli and suspended cells of Hypericum androsaemum. Plant Sci 150:93–101
Dias ACP, Seabra RM, Andrade PB, Ferreres F, Fernandes-Ferreira M (2001) Xanthone production in calli and suspended cells of Hypericum perforatum. J Plant Physiol 158:821–827
El-Mawla AMAA (2005) Xanthones from cell cultures of Hypericum gnidioides Seem. Bull Pharm Sci 28:105–111
El-Seedi HR, El-Barbary MA, El-Ghorab DMJ, Bohlin L, Borg-Karlson AK, Göransson U, Verpoorte R (2010) Recent insights into the biosynthesis and biological activities of natural xanthones. Curr Med Chem 17:854–901
Fotie J, Bohle SD (2006) Pharmacological and biological activities of xanthones. Anti-Infect Agents Med Chem 5:15–31
Franklin G, Conceição LFR, Kombrink E, Dias ACP (2009) Xanthone biosynthesis in Hypericum perforatum cells provides antioxidant and antimicrobial protection upon biotic stress. Phytochemistry 70:60–68
Gadzovska S, Maury S, Delaunay A, Spasenoski M, Hagège D, Courtois D, Joseph C (2013) The influence of salicylic acid elicitation of shoots, callus, and cell suspension cultures on production of naphtodianthrones and phenylpropanoids in Hypericum perforatum L. Plant Cell Tiss Org Cult 113(1):25–39
Gamborg OL, Miller RA, Ojima K (1968) Nutrient requirements of suspension cultures soybean root cells. Exp Cell Res 50:148–151
Ishiguro K, Fukumoto H, Nakajima M, Isoi K (1993) Xanthones in cell suspension cultures of Hypericum patulum. Phytochemistry 33:839–840
Ishiguro K, Nakajima M, Fukumoto H, Isoi K (1995) Co-occurence of prenylated xanthones and their cyclization products in cell suspension cultures of Hypericum patulum. Phytochemistry 38:867–869
Kitanov GM, Nedialkov P (1998) Mangiferin and isomangiferin in some Hypericum species. Biochem Syst Ecol 26:647–653
Komarovská H, Giovannini A, Košuth J, Čellárová E (2009) Agrobacterium rhizogenes-mediated transformation of Hypericum tomentosum L. and Hypericum tetrapterum Fries. Z Naturforsch C 64:864–868
Li W, Sun YN, Yan T, Yang SY, Choi CHW, Hyun WJ, Kang HK, Paek KY, Kim YH (2013) Isolation of xanthones from adventitious roots of St. John’s wort (Hypericum perforatum L.) and their antioxidant and cytotoxic activities. Food Sci Biotechnol 22:945–949
Loureiro J, Rodriguez E, Doležel J, Santos C (2007) Two new nuclear isolation buffers for plant DNA flow cytometry: a test with 37 species. Ann Bot 100:875–888
Mulinacci N, Giaccherini C, Santamaria AR, Caniato R, Ferrari F, Valletta A, Vincieri FF, Pasqua G (2008) Anthocyanins and xanthones in the calli and regenerated shoots of Hypericum perforatum var. angustifolium (sin. Frohlich) Borkh. Plant Physiol Biochem 46:414–420
Murashige T, Skoog F (1962) A revised medium for rapid growth and bioassays with tobacco tissue cultures. Physiol Plant 15:473–497
Nielsen H, Arends P (1979) Xanthone constituents of Hypericum androsaemum. J Nat Prod 42:301–304
Nürk NM, Madriňán S, Carine MA, Chase MV, Blattner FR (2013) Molecular phylogenetics and morphological evolution of St. John’s wort (Hypericum; Hypericaceae). Mol Phylogenet Evol 66:1–16
Pasqua G, Avato P, Monacelli B, Santamaria AR, Argentieri MP (2003) Metabolites in cell suspension cultures, calli, and in vitro regenerated organs of Hypericum perforatum cv. Topas. Plant Sci 165:977–998
Pasqua G, Monacelli B, Valletta A, Santamaria AR, Fiorillo F (2005) Synthesis and/or accumulation of bioactive molecules in the in vivo and in vitro root. Plant Biosyst 139:180–188
Pretto FR, Santarém ER (2000) Callus formation and plant regeneration from Hypericum perforatum leaves. Plant Cell Tiss Org 62:107–113
Rath G, Potterat O, Mavi S, Hostettmann K (1996) Xanthones from Hypericum roeperanum. Phytochemistry 43:513–520
Sobel JD (2007) Vulvovaginal candidosis. Lancet 369:1961–1971
Tala FM, Tchakam PD, Wabo HK, Talontsi FM, Tane P, Kuiate JR, Tapondjou LA, Laatsch H (2013) Chemical constituents, antimicrobial and cytotoxic activities of Hypericum riparium (Guttiferae). Rec Nat Prod 7:65–68
Tocci N, Ferrari F, Santamaria AR, Valletta A, Rovardi I, Pasqua G (2010) Chitosan enhances xanthone production in Hypericum perforatum subsp. angustifolium cell cultures. Nat Prod Res 24:286–293
Tocci N, Simonetti G, D’Auria FD, Panella S, Palamara AT, Valletta A, Pasqua G (2011) Root cultures of Hypericum perforatum subsp. angustifolium elicited with chitosan and production of xanthone-rich extracts with antifungal activity. Appl Microbiol Biotechnol 91:977–987
Tocci N, D’Auria FD, Simonetti G, Panella S, Palamara AT, Pasqua G (2012) A three-step culture system to increase the xanthone production and antifungal activity of Hypericum perforatum subsp. angustifolium in vitro roots. Plant Physiol Biochem 57:54–58
Tocci N, D´Auria FD, Simonetti G, Panella S, Palamara AT, Debrassi A, Rodrigues CA, Filho VC, Sciubba F, Pasqua G (2013) Bioassay-guided fractionation of extracts from Hypericum perforatum in vitro roots treated with carboxymethylchitosans and determination of antifungal activity against human fungal pathogens. Plant Physiol Biochem 70:342–347
Tocci N, Simonetti G, D’Auria FD, Panella S, Palamara AT, Ferrari F, Pasqua G (2013b) Chemical composition and antifungal activity of Hypericum perforatum subsp angustifolium roots from wild plants and plants grown under controlled conditions. Plant Biosyst 147:557–562
Tusevski O, Gadzovska Simic S (2013) Phenolic acids and flavonoids in Hypericum perforatum L. hairy roots. Int J Pharm Bio Sci 4:737–748
Tusevski O, Stanoeva JP, Stefova M, Kungulovski D, Pancevska NA, Sekulovski N, Panov S, Gadzovska Simic S (2013) Hairy roots of Hypericum perforatum L.: a promising system for xanthone production. Cent Eur J Biol 8:1010–1022
Tusevski O, Stanoeva JP, Stefova M, Gadzovska Simic S (2014) Agrobacterium enhances xanthone production in H. perforatum cell suspension. Plant Growth Regul. doi:10.1007/s10725-014-9989-6
Wolfle U, Seelinger G, Schempp CM (2014) Topical application of St. John's wort. Planta Med 80:109–120
Zdravkovic-Korac S, Calic D, Druart PH, Radojevic L (2004) The horse chestnut lines harboring the rol genes. Biol Plant 47:487–491
Acknowledgments
This work was partially supported by the Slovak Research and Development Agency under contracts No. APVV 0154-14, the Scientific Grant Agency of the Slovak Ministry of Education No. 1/0090/15, structural funds of EU (project KVARK 26110230084) and co-financed by grants from Sapienza Università di Roma (IT) protocol number: C26A11XLZ5 and C26A14RP98 and by the Project PON 01_01802.
Author information
Authors and Affiliations
Corresponding author
Ethics declarations
Conflict of interest
The authors declare that they have no conflict of interest.
Additional information
Communicated by M. Petersen.
Rights and permissions
About this article
Cite this article
Zubrická, D., Mišianiková, A., Henzelyová, J. et al. Xanthones from roots, hairy roots and cell suspension cultures of selected Hypericum species and their antifungal activity against Candida albicans . Plant Cell Rep 34, 1953–1962 (2015). https://doi.org/10.1007/s00299-015-1842-5
Received:
Revised:
Accepted:
Published:
Issue Date:
DOI: https://doi.org/10.1007/s00299-015-1842-5